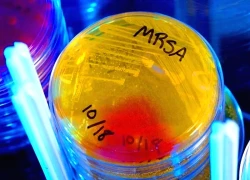
Phát hiện kháng sinh mạnh gấp 100 lần, mang hy vọng mới cho y học

Bé gái sơ sinh bị bỏ ở trạm điện cùng tờ giấy ghi tên và 15 triệu đồng
Một bé gái sơ sinh được phát hiện bị bỏ lại gần trạm điện ở xã Vạn An, tỉnh Nghệ An .
Bên cạnh em là giỏ đồ gồm quần áo , sữa, bỉm, thuốc bổ và 15 triệu đồng cùng tờ giấy ghi tên.
Sáng 23/9, ông Vương Hồng Thái, Chủ tịch UBND xã Vạn An (Nghệ An), xác nhận sự việc bé gái bị bỏ rơi trên địa bàn. Chính quyền đã phát thông báo rộng rãi, nếu sau 7 ngày không có người thân đến nhận, địa phương sẽ làm thủ tục cho nhận con nuôi theo quy định pháp luật .
Khoảng 5h15 ngày 22/9, trong lúc đi thể dục, anh L.N., trú tại xã Vạn An, phát hiện một bé gái sơ sinh bị bỏ lại bên đường gần trạm điện ở xóm Tiền Phong. Bên cạnh cháu có một giỏ đồ gồm vài bộ quần áo, sữa, bỉm, thuốc bổ, một tờ giấy và số tiền 15 triệu đồng.
Bé gái sơ sinh bỏ rơi bên đường ở xã Vạn An (Ảnh: Nguyễn Văn).
Ngay sau khi sự việc được trình báo, chính quyền địa phương đã tiếp nhận, đưa cháu bé đến Trạm Y tế xã để chăm sóc, kiểm tra sức khỏe . Qua thăm khám ban đầu của bác sĩ, sức khỏe cháu bé bình thường, nặng khoảng 4kg, giới tính nữ.
Video đang HOT
“Trong giỏ đồ có 15 triệu đồng và một tờ giấy ghi thông tin cháu bé. Nội dung cho biết cháu tên gọi là Nấm, do hoàn cảnh không thể nuôi dưỡng nên nhờ ai nhặt được thì chăm sóc giúp. Hiện sức khỏe bé ổn định, rất kháu khỉnh”, ông Thái nói.
Cũng theo ông Thái, bé gái được xác định khoảng 20 ngày tuổi. Chính quyền xã đang hoàn tất các thủ tục cần thiết, đồng thời thông báo trên các phương tiện thông tin đại chúng để tìm người thân cháu bé.
Người lái xe kể lại khoảnh khắc bị nhồi máu cơ tim giữa trưa hè
Trong buổi trưa nắng nóng gay gắt, ông Đ.H.L. (48 tuổi, trú tại Tây Ninh), bất ngờ đối mặt với cơn nhồi máu cơ tim khi vừa hoàn thành việc bốc dỡ hàng hóa.
90% là tử vong
Khoảng 9h sáng 9/5, ông L. vừa hoàn thành việc bốc dỡ hàng hóa cho công ty và trở về rửa xe. Khi chuẩn bị bước lên cabin, ông đột nhiên cảm thấy hoa mắt, không nhìn rõ xung quanh. "Mắt tôi như bị ánh sáng chói lóa che mờ, ngực đau thắt, mồ hôi tuôn ra như nước. Tôi nghĩ mình khó qua khỏi", ông L. nhớ lại khoảnh khắc kinh hoàng.
Những người xung quanh nhanh chóng đưa nam bệnh nhân đến trạm y tế xã và báo cho gia đình. Mẹ ông L. kể lại, bà hoảng hốt chạy đến trạm y tế và chứng kiến con trai trong tình trạng nguy kịch: "Con tôi không uống được thuốc, mồ hôi vã ra như tắm, lau khô lại ướt ngay".
Nhận thấy tình hình nghiêm trọng, gia đình lập tức chuyển ông L. đến Bệnh viện Đa khoa huyện Củ Chi. Tại đây, các bác sĩ nghi ngờ người bệnh bị nhồi máu cơ tim cấp, nguy cơ tử vong lên đến 90%. Nếu may mắn cứu được, ông có thể phải sống thực vật nửa đời còn lại.
Không bỏ cuộc, gia đình quyết định đưa ông L. đến một bệnh viện có đủ khả năng cấp cứu nhồi máu cơ tim. Tại đây, ông được chẩn đoán nhồi máu cơ tim cấp ST chênh lên thành dưới thất phải, giờ thứ 6, kèm biến chứng ngưng tuần hoàn hô hấp.
Các bác sĩ đang can thiệp cho bệnh nhân. Ảnh: BSCC.
Bác sĩ Nguyễn Quốc Trí, chuyên khoa Can thiệp Tim mạch, người trực tiếp cấp cứu cho ông L, cho biết: "Đây là một ca đặc biệt. Kết quả chụp động mạch vành ghi nhận nhiều huyết khối trong lòng mạch, đòi hỏi can thiệp khẩn cấp".
Ê-kíp lập tức tiến hành hút huyết khối và đặt 3 stent vào động mạch vành phải để tái thông mạch máu. Tuy nhiên, ông L. vẫn đối mặt với nguy cơ tổn thương đa cơ quan, đặc biệt là tổn thương não do ngưng tuần hoàn. Sau 4 ngày điều trị tích cực, ông L. dần tỉnh lại từ trạng thái hôn mê.
Theo bác sĩ Trí, thành công của ca cấp cứu đến từ ba yếu tố: Sự phối hợp nhịp nhàng và nhanh chóng của ê-kíp y tế, quyết tâm của gia đình khi bệnh nhân còn trẻ, sức chịu đựng tốt của ông L. nhờ độ tuổi chưa quá cao. "Bệnh nhân trẻ thường có cơ hội hồi phục cao hơn so với người lớn tuổi", bác sĩ Trí nhấn mạnh.
Sau 10 ngày được chăm sóc tích cực, ông L. đã hồi phục hoàn toàn. Ông tỉnh táo, ăn uống, đi lại bình thường và đặc biệt không mất trí nhớ.
"Tôi mừng lắm, cứ ngỡ không qua khỏi, vậy mà giờ đây mọi thứ đều ổn", ông L. chia sẻ.
Dấu hiệu nhồi máu cơ tim
Nhồi máu cơ tim là bệnh lý nghiêm trọng xảy ra khi một hoặc nhiều nhánh động mạch vành bị tắc nghẽn, khiến cơ tim thiếu máu nuôi dưỡng và dần hoại tử.
Triệu chứng điển hình bao gồm đau thắt ngực dữ dội, lan tỏa đến cánh tay, vai, cổ, hàm hoặc vùng bụng, kèm theo mồ hôi lạnh, buồn nôn, khó thở, chóng mặt, và thậm chí bất tỉnh. Các triệu chứng có thể khác nhau tùy thuộc vào tuổi, giới tính, vùng tổn thương và các bệnh lý nền.
Theo bác sĩ Trí, nếu không được cấp cứu kịp thời, vùng cơ tim hoại tử sẽ hình thành sẹo sau vài tuần, làm tăng nguy cơ suy tim và các biến chứng nguy hiểm khác.
Bác sĩ khuyến cáo, khi nghi ngờ nhồi máu cơ tim, bệnh nhân cần được đưa ngay đến các cơ sở y tế có chuyên khoa can thiệp tim mạch để thực hiện các xét nghiệm như điện tâm đồ, siêu âm tim, xét nghiệm men tim.
Hiện tại, ông L. tiếp tục được theo dõi và điều trị suy tim, sử dụng thuốc chống tập kết tiểu cầu và thuốc kiểm soát mỡ máu. Các chỉ số thận, gan của ông đều ổn định.
Trải qua cơn thập tử nhất sinh, ông L. giờ đây trân trọng từng khoảnh khắc được sống và nhắc nhở mọi người xung quanh về tầm quan trọng của việc nhận biết và xử trí kịp thời các dấu hiệu nhồi máu cơ tim.
Chuyện đau lòng về bức ảnh người đàn ông "chết lặng" ở hành lang viện
Người đàn ông ngoài 30 tuổi tranh thủ lúc đưa vợ đi khám thai để kiểm tra sức khỏe tổng quát và bất ngờ phát hiện ung thư dạ dày đã di căn. Ngày 3/6, hình ảnh người đàn ông ngồi trên ghế, tựa đầu vào hành lang bệnh viện sau khi nhận tin dữ được một nhân viên y tế ghi lại...
Bão Kalmaegi giật cấp 13 vào Biển Đông, sức tàn phá dữ dội bao trùm miền Trung03:04
Chồng của Đoàn Di Băng bị bắt tạm giam, nghi án 'hàng giả' lớn nhất Đồng Nai?02:47
Bão Kalmaegi đi qua để lộ tàu cổ ở Hội An, chuyên gia ngỡ ngàng vì sự thật sốc02:43
Khoảnh khắc trực thăng Nga đập mạnh xuống đất, gẫy đuôi làm 5 người chết08:21
Cầu rung lắc dữ dội giữa siêu bão Phượng Hoàng ở Philippines31:22Tiêu điểm
Tin đang nóng
Tin mới nhất

Gần 300 ca nghi ngộ độc liên quan "bánh mì cóc cô Bích", xét nghiệm thấy thêm vi khuẩn

Mắc ung thư phổi dù cả đời chưa từng cầm điếu thuốc
Phát hiện kháng sinh mạnh gấp 100 lần, mang hy vọng mới cho y học

Lá xương sông có tác dụng gì?

Đi bộ mỗi ngày giúp sống thọ hơn

Tình trạng viêm có thể gây khởi phát ung thư phổi ở giai đoạn sớm

Cách tốt nhất để thải độc tự nhiên giúp tăng cường sức khỏe

8 loại hạt giàu magie nên ăn để giúp ngủ ngon

Hàng chục người nghi ngộ độc sau bữa cơm trưa tại công ty

Gia Lai ghi nhận 8 ca tử vong do bệnh dại

Hàng trăm người đi cấp cứu sau ăn bánh mì: Chưa thể kết luận do Salmonella

Nồm ẩm trái mùa gây hại sức khỏe thế nào
Có thể bạn quan tâm

Ca sĩ Tuấn Hưng lên tiếng về thông tin đang ốm nặng, mất giọng
Sao việt
23:02:52 11/11/2025
Tài tử 81 tuổi của 'Squid Game' được tuyên vô tội sau cáo buộc quấy rối tình dục
Sao châu á
23:00:31 11/11/2025
Ca sĩ bolero học đại học ở tuổi ngoài 40, tiết lộ cuộc sống kín tiếng
Tv show
22:53:02 11/11/2025
Văn Lâm chấn thương trong buổi tập đầu tiên của tuyển Việt Nam
Sao thể thao
22:48:42 11/11/2025
Đánh giá 1 sao khách sạn Hàng Cháo 'đuổi khách' là vô nghĩa
Netizen
22:44:54 11/11/2025
Lời khai của Nguyễn Thị Hoàng- đối tượng trộm sợi dây chuyền gần 6 chỉ vàng
Pháp luật
22:41:15 11/11/2025
Tài xế ô tô nghi bị tấn công vì không xoá clip đốt pháo: Chính quyền lên tiếng
Tin nổi bật
22:32:55 11/11/2025
Phát hiện thi thể vợ chồng triệu phú Nga trên sa mạc ở Dubai
Thế giới
22:24:40 11/11/2025
Minh Hằng không nghĩ quá nhiều về chi phí khi làm MV
Nhạc việt
21:40:09 11/11/2025
Cách nấu bún bò thố đá thơm ngon đơn giản
Ẩm thực
21:35:14 11/11/2025
Nam thanh niên bị đứt lìa khí quản vì vướng vào dây điện giữa đường
10 loại trái cây giúp trái tim khỏe mạnh
Người phụ nữ Indonesia nhiễm trùng sau phẫu thuật thẩm mỹ tại TPHCM
Cành cây dài 20cm nằm trong lồng ngực bệnh nhân hơn 2 năm
4 người gắn vòng ở vùng kín để tăng khoái cảm, phải dùng máy khoan cấp cứu
Từ chối tiêm vaccine sởi cho trẻ, nguy cơ tử vong rình rập
Đau bụng đến bất tỉnh nguy kịch vì căn bệnh hiếm chỉ 0,06% dân số gặp phải
Cảnh báo về sự nguy hiểm của bệnh não mô cầu
Cô gái sơ ý nuốt cả viên thuốc còn nguyên vỏ sắc cạnh
Khối u nặng 5kg nằm trong bụng người đàn ông
Lộc Bình: Hơn 1.100 người cao tuổi được truyền thông, khám sức khỏe
Lý do bất ngờ khiến bé trai 4 tuổi bị chảy máu cam kéo dài
Cứu sống thai nhi bị suy thai do 5 vòng dây rốn quấn chặt
Cảnh báo 'đỏ' về trào lưu lạm dụng thuốc bổ: Âm thầm rước họa vào thân
Người già ngày nào cũng uống vitamin có sao không?
Nguyên nhân khiến nữ sinh bụng to nhanh như mang bầu 9 tháng
'Con dao hai lưỡi' mang tên vitamin
3 cách xả stress căng thẳng đơn giản mà hiệu quả
Tử vong sau 2 tuần ho, sốt vì loại khuẩn hay gặp
Bổ sung vitamin cho người cao tuổi có thực sự cần thiết
Đến viện tái khám muộn, người đàn ông đột quỵ ngay trước mặt bác sĩ
Bữa nhậu suýt cướp mạng sống người đàn ông 32 tuổi
Người đàn ông hoại tử vùng kín sau một tháng 'độ hàng'
Phẫu thuật khối bướu khổng lồ gây biến dạng vai gáy cho bệnh nhân
Cô gái hôn mê bỗng tỉnh lại sau 2 năm, bác sĩ gọi là "kỳ tích"
Vụ 3 ngư dân trôi dạt 48 giờ: Vì sao một người bị viêm đường ruột nặng?
Một loại rau được bác sĩ tim mạch khuyên ăn càng nhiều càng tốt
4 thay đổi ở vùng bụng chứng tỏ khối u 'núp' bên trong, ai không để ý thì người đó thiệt!
Không phải tỏi, loại củ rẻ hơn rau cũng giúp phòng cúm A
3 loại đồ uống giúp kéo dài tuổi thọ, giảm nguy cơ tử vong
Hai tuần đầu 'địa ngục' của người uống thuốc trầm cảm
10 loại thực phẩm cực bổ thận bạn nên ăn thường xuyên
Vụ khách sạn Royal Hotel từ chối khách lúc 2h:Cơ sở vi phạm hàng loạt lỗi
Nữ ca sĩ 24 tuổi bị nhân tình hơn 30 tuổi sát hại dã man ở khách sạn
Bác sỹ tắc trách, bệnh nhân suýt bị mổ lấy tạng hiến ngay khi còn sống
NSND Huỳnh Tú: 'Tôi đau đáu suốt gần 60 năm qua vì con trai Soobin'
Nhân viên ngân hàng tá hỏa vì 1,8 tỷ đồng để trong cốp xe máy biến mất
'Kiều nữ làng hài' từng 4 lần gặp lừa đảo, U60 nhận là 'tân binh có thâm niên'
Ly Kute mang thai lần thứ ba
Hà Nội: Nữ sinh khống chế kẻ sàm sỡ giữa bến xe Mỹ Đình
Bên trong căn nhà Viết Vương và Hoa hậu Đỗ Hà sẽ ở sau khi cưới
Một CEO công nghệ ở TP HCM đột ngột qua đời
Lãnh đạo Trường THPT - nơi người đàn ông có clip "thân mật" với nhiều phụ nữ - nói gì?
Một Anh Trai nói đùa nhưng không vui, còn buông lời khiếm nhã với fan G-DRAGON rồi vội vàng xóa đi
Xôn xao clip vụ mẹ chồng đè lên người, nắm tóc con dâu mới sinh gây phẫn nộ
Cuộc đời nữ NSƯT là mẹ của ba mỹ nhân màn ảnh Việt, giờ không còn nhận ra con gái út
Chị gái Đỗ Hà đăng ảnh với chồng trong lễ cưới em gái, bất ngờ vấp tranh cãi
Công an xác minh vụ cô gái bị khách sạn ở Hà Nội từ chối nhận phòng lúc 2h
Toàn cảnh vụ nữ du khách đến trễ, bị khách sạn trên phố Hàng Cháo từ chối lúc 2h sáng dù đã trả full tiền
5 cặp đôi phim giả tình thật đẹp nhất Việt Nam: Trấn Thành - Hari Won xếp thứ 2, hạng 1 đúng chuẩn "tiên đồng ngọc nữ"